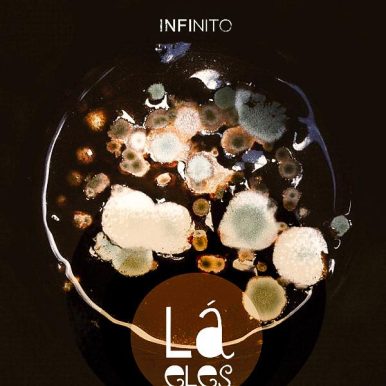
Lá Eles – Infinito EP

Lá Eles – Infinito EP
O primeiro disco oficial do Lá Eles, ‘Infinito’, é uma verdadeira odisséia musical. Composto por Beto Wilson, Ivanzinho e Felipe Pomar, o EP une a riqueza da música brasileira regional a elementos de diversas partes do mundo, criando uma experiência sonora única e inovadora. ‘Infinito’ não tem início nem fim, explorando nuances e recomeçando constantemente, provando que a música não conhece limites. Uma obra que transcende, experimenta e incorpora, convidando o ouvinte a navegar pelos ventos calmos do universo musical em qualquer direção. Ouça e descubra a beleza e a liberdade que este álbum oferece.
Para ouvir melhor...




Veja também

PRAIA FUTURO – Praia Futuro
Lançamento
2017

Vitor Araújo – Levaguiã Terê
Lançamento
2016

Sebastião Tapajos & Pedro Dos Santos – Volume. 1
Lançamento
1972

Rodrigo Samico – Voyage dans l’espace temps suspendu
Lançamento
2021

Ave Sangria – Ave Sangria
Lançamento
1974

Rafael Castro – Vaidosos Demais
Lançamento
2024

Meno del Picchia – Maré Cheia
Lançamento
2024

Gui Amabis – Contrapangeia
Lançamento
2024

Vhoor – Baile & Bass
Lançamento
2022

Ná Ozzetti – Embalar
Lançamento
2013


Hurtmold – Mestro
Lançamento
2004

Furmiga Dub – Grave na mata, Vol 2
Lançamento
2023

Ex-Exus – Xô
Lançamento
2013

Braza – Braza
Lançamento
2016

DELÍRIO CABANA – Delírio Cabana
Lançamento
2025
Para ouvir melhor...